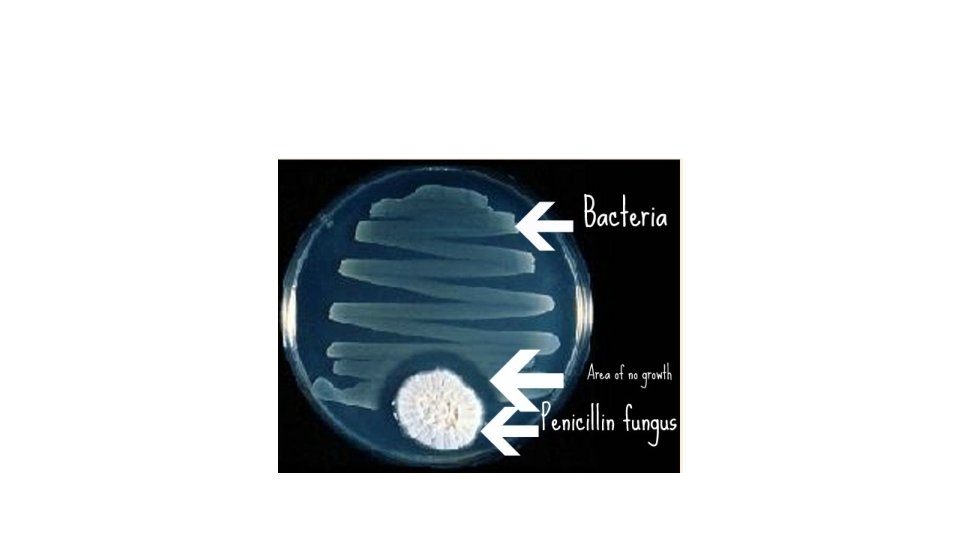

Classification Viruses Bacteria Archaea Protists Fungi Bacteria Eubacteria

Classification Viruses, Bacteria, Archaea, Protists, Fungi

Bacteria

Eubacteria Structure • Unicellular, prokaryotic organisms • Large circular chromosome • Cell walls (peptidoglycan) • Cell wall prevents osmotic (water) rupture.

Prokaryotes are the foundation of life on earth • Decompose dead organisms • Decomposers, saprobes, saprophytes • Put good nitrogen into air • Live in our digestive system and are also used in the food industry • Cheese, yogurt, etc • Used to decompose waste in sewage • Disesase causing bacteria – Usually produce toxins. Exbacteria that causes botulism (paralyzes nerve cells)

Some Prokaryotes Cause Disease • Bacterial Examples: cholera, diphtheria, leprosy, Lyme disease, meningitis, the plague, pneumonia, syphilis, gonorrhea; tetanus, tuberculosis, strep throat. See book for more. • Antibiotics are the most effective means of fighting bacterial infections • Penicillin breaks down cell wall and allows rupture • **No known Archaea cause disease

Archaea

Major Groups of Archaea • Extremophiles-3 types • Methanogens: are poisoned by oxygen • use CO 2 as the electron acceptor in respiration • produce methane as a waste product • Halophiles- lives in very saline places • Thermophiles (aka

Archaeabacteria vs eubacteria • Used to be grouped with bacteria and called Monerans • Now believed eukaryotes “split” from archaeal line of descent • Differences between Arch and Bac: • Archaea have “unusual” diverse lipids in membrane that allow them to live under extreme conditions • Cell walls composed of polysacc and some only are entirely protein. **A few recently discovered have no wall (not on test, just FYI) • Similarities between Arch and Euk: • Arch and Euk share some of the same r. RNA sequences and ribosomal proteins • Similar t. RNA • Some Archaea have introns; bacteria do not

The Origin of the Eukaryotic Cell • Eukaryotic cells arose through a combination of 2 processes: • Membrane Infolding: • Produced all the membrane-bound organelles except the mitochondrion and the chloroplasts. • Endosymbiosis: • Mitochondria and chloroplasts once prokaryotic cells that were ingested or absorbed by other cells.

Protista

Kingdom Protista • Very diverse group of organisms • Currently being phylogenetically reclassified based on common DNA sequences, proteins, and therefore common ancestors • Most are unicellular • The most elaborate cells of all the kingdoms

Kingdom Protista • Most are aerobic & use mitochondria for respiration • Some are autotrophs, some are heterotrophs • 3 types: ingestive, absorptive, photosynthetic.

Amoeba- moves and ingests using pseudopodia

Ciliates Paramecium- has both a macro and micro nucleus, so it has a “reserve” copy of genome. Macro regulates metabolism and micro is used in conjugation.

Flagellates Euglena- unique flagellate. Both autotrophic and heterotrophic

Diatoms Contain silica “shells”- forms diatomaceous earth

Volvox- single cells, but colonial

Red Tide

More Plant-Like Protists • P. Phaeophyta – the brown algae • include the largest seaweeds, the kelps (**multicellular) • P. Rhodophyta – the red algae • include the red seaweeds, some encrusted and common in coral reefs

Fungi

What is a fungus? • Most are multicellular • Cell walls made of chitin. • Heterotrophic • Nonphotosynthetic • Digest food outside bodies (using enzymes) and absorb it • Some live off of dead organic matter • Decomposers

Structure and Function of Multicellular Fungi • Composed of tiny filaments called hyphae • Hyphae are long strings of cells. Mass called mycelium. Some species can grow a km of hyphae/day! • Can reproduce asexually by releasing haploid spores • Unicellular fungi-yeast • Multicellular ex: mushrooms, molds

Ecological Impacts of Fungi • Decomposers! Important nutrient recyclers • Some are pathogens, such as ringworm and athletes foot. Plant pathogens--Dutch elm disease, Chestnut blight • Some produce deadly toxins-ex-some species of mushrooms • We use them for their antibiotics-penicillium. Produce enzymes that rupture bacterial cell walls
- Slides: 24